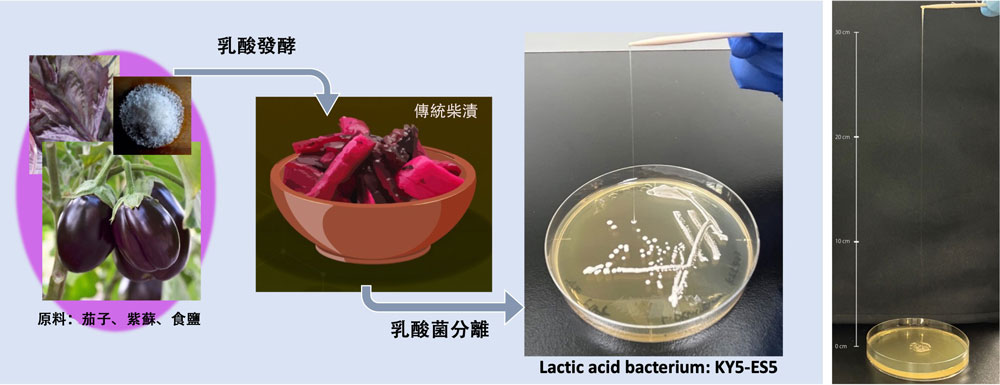
title

京都的傳統醃菜「柴漬」中發現了一種新型乳酸菌。該菌株由東京科學大學生命理工學院的山田拓司教授與GURUNAVI公司的澤田和典博士等人組成的研究團隊發現。新發現的乳酸植物桿菌(Lactiplantibacillus plantarum)KY5-ES5能產生含甘油的新型胞外多醣(EPS),EPS是決定食品「濃稠度」與「順滑度」的關鍵成分。相關研究成果已發表在期刊《Microbiology Spectrum》上。本研究系東京科學大學與GURUNAVI公司的合作研究。
圖1. 從京都柴漬醃菜中分離出來的特定乳酸菌(左)。展現極高粘度的KY5-ES5菌株(右)(供圖:東京科學大學)
為避免受到培養基中使用的天然物成分的影響,研究團隊採用合成培養基進行培養,並對該菌株產生的胞外多醣(EPS)進行了詳細分析。首先,高效液相層析術顯示EPS由葡萄糖、半乳糖、甘油等單醣構成,比例約為6:3:1。而含有甘油的EPS此前幾乎未見報導。通過核磁共振(NMR)分析進一步證實,該EPS中的單醣以多種結合方式連接,具有分支結構及甘油磷酸修飾特徵。這種獨特結構表明EPS可能產生高粘度與順滑口感。
此次闡明的新菌體外多醣,可以自然提升植物性酸乳、發酵飲料等食品的口感,有望改善發酵食品的品質。由於無需使用化學添加劑即可賦予產品濃稠度與順滑感,有望為近年來需求激增的注重無添加劑的清潔食品的開發作出貢獻。此外,由於該乳酸菌產生的EPS具有前所未有的結構特徵,因此未來可能揭示其免疫調節、抗氧化等新型功能性,成為發酵食品功能性的重要基礎。
今後,研究團隊將深入研究新發現的EPS功能,探索其是否具有調節腸道環境、緩解氧化壓力、平衡免疫系統等潛在功能。同時計畫推動其在植物性發酵飲料及替代乳製品領域的產業應用。
原文:《科學新聞》
翻譯:JST客觀日本編輯部
【論文資訊】
期刊:Microbiology Spectrum
論文:Influence of the initial microbiota on eggplant shibazuke pickle and eggplant juice fermentation
DOI:10.1128/spectrum.00464-24













